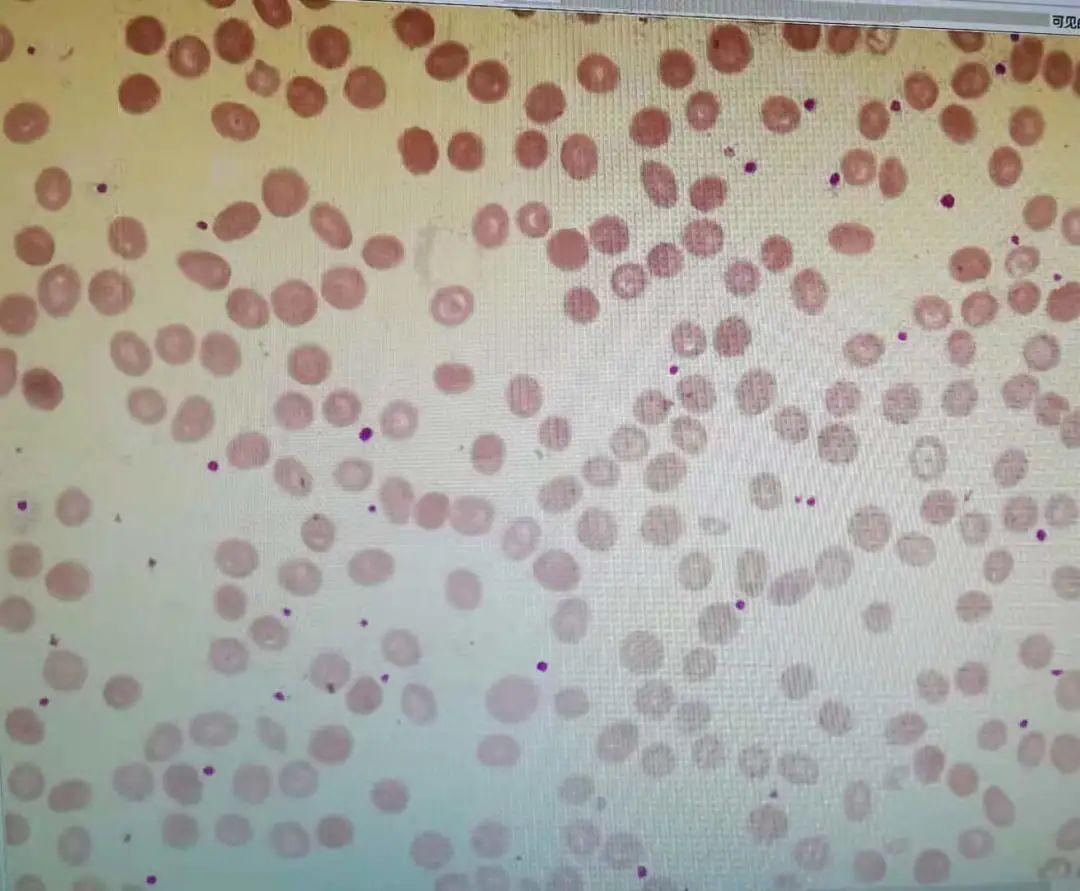
贫血补铁有用吗(贫血补铁用有副作用吗)-硒宝网

贫血补铁有用吗(贫血补铁用有副作用吗)
单位:1.川北医学院附属医院检验科 2.川北医学院附属医院血液科
前 言
缺铁性贫血是最常见的儿童贫血类型,根据2011年WHO报告,估计铁剂补充可以提高6-59月龄婴幼儿血红蛋白水平8g/L,并可以控制42%的贫血[1]。因此在很多基层医院发现儿童贫血,就给予补铁治疗,贫血的孩子只要多补铁就对了吗?
案例经过
某天上午,上班时,接到一患者家属抱怨电话:医生,我孩子服用多糖铁三个多月了,怎么血常规检查结果与三个月前变化不大?你们检查是不是有误?接到电话,我们立即对患儿的血常规进行了复查:结果无误,血常规结果及仪器报警信息如图1:

图1
仪器报警提示:小红细胞,血小板直方图翘尾,疑是小红细胞干扰。推片复检发现患儿血片中小红细胞易见,可见靶形红细胞。如图2所示:
图2
遂告诉家属检测无误,根据患儿血常规及形态检查,患儿极可能是地中海贫血,建议到我院血液科或儿科门诊就诊。后对该病例进行追踪:该患儿6岁,在当地县医院就诊时,医生诊断缺铁性贫血,给予补铁治疗,三个月后家长带患儿到上级医院复查,发现血常规检测结果与上次检查无明显变化,才有之前的疑问。之后患儿在我院做了进一步检查:

▲贫血四项检查

▲血红蛋白电泳

▲地贫基因检测
由此该患儿诊断轻型β地中海贫血明确,嘱咐患者停止补铁,门诊随访。
检验案例分析
该患儿血常规表现出小细胞低色素性贫血,基层医院在没有进一步检查的情况下易误诊断为缺铁性贫血,往往经验性的给予补铁治疗,而事实上小细胞低色素性贫血就是缺铁贫吗?
显然不是,仔细分析患儿的血常规结果,RDW 正常,属于小细胞均一性贫血,缺铁性贫血往往表现出小细胞非均一性贫血;血涂片镜检发现患儿血片中可见靶形红细胞,不支持缺铁贫;轻度缺铁贫红细胞形态无明显异常,中度以上贫血时红细胞体积减小,中央淡染区扩大。
因此基层医院在无进一步检查情况下,更应重视血常规形态学显微镜镜检,从细胞形态学异常发现疾病的蛛丝马迹。同时应重视仪器报警信息的拦截,本例仪器报警:小细胞性红细胞、血小板直方图异常,应推片复检确认。
再根据文献报道[2-3] :MCV/RBC≥13.0 鉴别轻型地中海贫血和轻型缺铁性贫血有很好的应用价值,即MCV/RBC,13则提示为缺铁性贫血。本例患儿MCV/RBC为11.13,地贫 < 13,因此在检查技术缺乏的基层医院,采用血常规参数MCV/RBC 比值联合 MCV 和 RDW 筛查、鉴别轻型地中海贫血和缺铁性贫血具有简便、快速、经济的特点,值得推广应用。
患儿针对贫血原因四项检查,血清铁蛋白结果正常,排除缺铁性贫血,患儿基因检测显示β珠蛋白基因41-42位点杂合突变,属于轻型β地中海贫血。其父母随后也在本院进行了地贫基因筛查发现其父亲为β地贫基因携带者,母亲正常,由于平日生活无异常,所以并未进行产前诊断及遗传咨询,孩子在偶然感冒后查出轻度贫血,在县医院医生给与了经验性的补铁治疗,无效。这才到上级医院排查。
临床案例分析
地中海贫血的诊断主要依据临床表现、血液学改变、遗传学检查和分子生物学分析四个方面来确定。临床血液学改变,除了血液学常规检查外,血红蛋白电泳检查是诊断本病的必备条件,本例患儿男,6岁,发育可,皮肤巩膜无黄染,全身无出血点及瘀斑,肝脾肋下未及。
根据患儿的实验室检查及父母基因地贫基因筛查结果可诊断轻型β地中海贫血明确。本病尚无根治的方法,无贫血或轻度贫血一般不需治疗,对诱发溶血的因素如感染应积极防治。
知识拓展
地中海贫血又称海洋性贫血(简称地贫),是一组遗传性溶血性贫血。其共同特点是由于珠蛋白基因的缺陷使血红蛋白中珠蛋白的珠蛋白肽链有一种或几种不能合成减少或不能合成,导致血红蛋白的组成成分改变。
我国以广东、广西、海南、四川、重庆等省区发病率较高,北方较为少见。笔者所在地区四川正是地贫的高发区,应警惕地贫的可能,轻型地贫无需特殊治疗,盲目补铁有害无益。
一、地贫分型及临床表现
根据珠蛋白肽链合成障碍的种类不同,通常将地贫分为α型、β型、δβ型和δ型4种,其中以α和β地中海贫血较为常见,其常见基因型与表型见表1,表2[4]。
表1 β地贫常见基因型与表型的关系

表2 α地贫常见基因型与表型的关系

二、地贫须与下列疾病鉴别
1. 缺铁性贫血
轻型地中海贫血的临床表现和血常规检查结果有相似之处,故易被误诊。主要鉴别点如下:

2. 传染性肝炎或肝硬化
因HbH病贫血较轻,还伴有肝脾肿大、黄疸,少数病例还有肝功能损害,故易被误诊为黄疸型肝炎或肝硬化。但通过病史询问、家族调查以及红细胞形态观察,血红蛋白电泳即可鉴别。
三、地中海贫血的孩子需要补铁吗?
一般不需要,地中海贫血孩子大都体内铁元素充足或过量,原因为地贫孩子自身红细胞有病理特征,寿命缩短,破坏增多,释放出铁元素。经过反复多次输血,输注的红细胞在死亡后,同样会释放出铁元素。过多的铁元素沉积到心、肝、肾等脏器,会造成脏器功能不良。正规输血治疗的地中海贫血患者,同时需进行驱铁治疗。
四、地中海贫血的实验室检查
1.血常规检查
当患者的血液常规检查中MCV
2.血红蛋白电泳分析
主要看各血红蛋白组分的比例(A、F、A2),是否有异常的条带,若血红蛋白电泳结果出现HbA23.5,则应怀疑为β地贫基因携带者,若F值明显升高,提示δβ地贫,若出现H带,提示HbH?。蝗舫鱿忠斐L醮?,提示异常Hb。
3.地贫基因诊断
需注意基因诊断依旧存在局限性,检查结果如是阳性,说明所测样品中含有此种突变,如果是阴性结果只能说明所检测样本中不含所检测的突变类型,必要时可根据受检个体表型做进一步基因缺陷类型检测。
五、如何预防地中海贫血
地贫是一种遗传性溶血性疾病。遗传风险最高的夫妻组合是一名地贫基因携带者跟另一名地贫基因携带者结婚。婚前、孕前、产前进行地贫基因筛查是降低重型地贫患儿出生率的最佳措施。
案例总结
贫血的孩子多补铁就对了吗?显然不对,不是所有的贫血都是缺铁,一定要查明病因。地中海贫血的孩子通常都不缺铁,甚至是过量的,所以不能盲目补充铁剂治疗,过多摄入铁有害无益。在基层医院,医生往往凭经验性的治疗,容易误诊,本案例梳理了地贫与缺铁贫的区别,地贫的实验室检查等,希望能给临床提供帮助!
专家点评
地中海贫血与缺铁性贫血同属于小细胞低色素性贫血,在临床上易混淆,通过实验室贫血原因筛查、血红蛋白电泳、地贫基因检查很容易将二者区分。在实验室检查不完善的基层医院可通过血常规参数MCV/RBC比值联合MCV和RDW进行筛查,也可根据异常红细胞形态发现一些蛛丝马迹,建议基层医院重视血涂片镜检,让患者少走弯路,减轻诊治经济负担。
(点评专家:刘文副主任检验技师,川北医学院附属医院检验科临检组组长)
参考文献
[1]Stevens GA, Finucane MM, De-Regil LM, Paciorek CJ, Flaxman SR, BrancaF, Pe?a-Rosas JP, Bhutta ZA, Ezzati M. Nutrition Impact Model StudyGroup (Anaemia). Global, regional, and national trends in haemoglobinconcentration and prevalence of total and severe anaemia in childrenand pregnant and non-pregnant women for 1995-2011: a systematicanalysis of population-representative data. Lancet Glob Health. 2013Jul;1(1):e16-25.
[2]Jain S, Kamat D. Evaluation of microcytic anemia. Clin Pediatr(Phila). 2009;48(1):7-13.
[3]Sazawal S, Dhingra U, Dhingra P, et al. Efficiency of red celldistribution width in identification of children aged 1-3 years withiron deficiency anemia against traditional hematological markers. BMCPediatr. 2014;14:8.
[4]吴学东,徐肖肖,朱易萍.地中海贫血分类及诊断规范[J].中国实用儿科杂志,2018, 33(12): 957-961.
